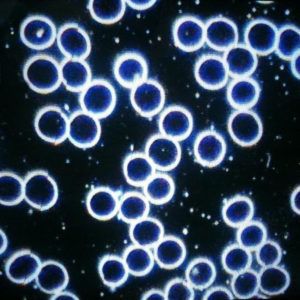
ON-Blog-Live-Cell-Microscopy-healthy-blood-cells

Live Cell Microscopy (LCM) was researched over 140 years ago. However, only with advances in technology such as a video camera and computer connected to the microscope, a client can have their sample taken and viewed right away. The analysis has been successful in helping clients make changes to their nutritional habits and motivating them to improve their lifestyle with a goal in mind of optimal health. This is not only achieved through proper food planning, but with the addition of specific supplements as well.
Live Cell Analysis is a valuable process that shows the early development of imbalances in the terrain or even compromised immune function many months or years prior to any medical diagnosis.
How Live Cell Microscopy works
The process involves taking a drop of blood from the finger using a lancet and placed on a covered slide, then viewed under a specialized microscope. This method differs from traditional blood tests that involve laboratory analysis because in order for cellular structures to be seen with their processes, it is necessary to be stained. When viewing the live cells under the microscope using a darkfield or brightfield condenser, the image is a highly contrasted live image magnified 800 times or more, which can then be evaluated.
This process is not used to confirm the presence of disease nor diagnose or treat. Rather, this is used as an educational and nutritional tool along with the client’s symptomatology to determine lifestyle and nutritional changes necessary for health improvement. Live cell analysis looks at the cellular structures in view, such as the red blood cells, white blood cells, platelets, and any additional undesirable fungal or bacterial by-products, incomplete or delayed digestion, liver congestion or toxic metabolic wastes. Looking at the red blood cells in this manner reflects nutritional status, such as low iron, fatty acids, vitamin B12, adrenal insufficiency, and even damaged cells due to free radicals, oxidative systemic stress and dysbiosis.
The basics of blood
The bloodstream runs in a similar way to that of a river, transporting nutrients and oxygen throughout the body. It is also a medium for detoxification via the transport of wastes through the liver and kidneys for elimination. It is better to be a fast-flowing river than a stagnant swamp in order to maintain optimal health.
Here, you can see a comparison of images between healthy and unhealthy blood cells.
Healthy blood
Consistent, round shape without variations in size and are not stuck together, more evenly dispersed. The space around the cells is mostly clear and every cell looks even with excellent membrane integrity.
Unhealthy blood
Cells are not seen clearly in this image due to cellular breakdown and the nature of the terrain.
To prepare for an appointment, clients are asked not to consume food at least 3 hours prior, and to drink at least 3 cups of water to ensure they are well hydrated. The test is done on an empty stomach because after eating, once nutrients enter the bloodstream, it becomes more difficult to observe the surrounding areas around the cells. This assessment along with other collected information can be very valuable as a predicator of current health and in the early assessment of determining an unbalanced terrain, compromised immunity and environmental / chemical sensitivity years or months prior to a medical diagnosis.
A unique perspective
Biochemical individuality is the term that defines how we differ nutritionally. We all require nutrients from the same food groups, but we d not require them in the same proportions or even from the same source. Out ability to digest, absorb and assimilate nutrients varies from person to person. Being able to take a ‘look’ inside via Live Cell Analysis gives us an opportunity to make lifestyle and nutritional changes, and motivates us to implement and monitor those changes.
Guest Author:
Reesa Mustafa, RNCP, ROHP
Reesa’s personal journey started about a decade ago when she managed to solve some of her own health issues and thus, led her into the world of Holistic Wellness. She discovered her passion to share this knowledge with others, and began her studies to be certified as a Holistic Nutritionist. Fully committed to learning and supporting her clients, Reesa went on to complete additional programs and is now a Registered Orthomolecular Health Practitioner and Live Cell Microscopist. Her eagerness to discover more about holistic wellness continues as she studies with various professionals around the world while continuing to support clients. Reesa enjoys growing her own food year-round and lives in the Greater Toronto Area with her family.
Learn more about Reesa at wholesomeliving.ca